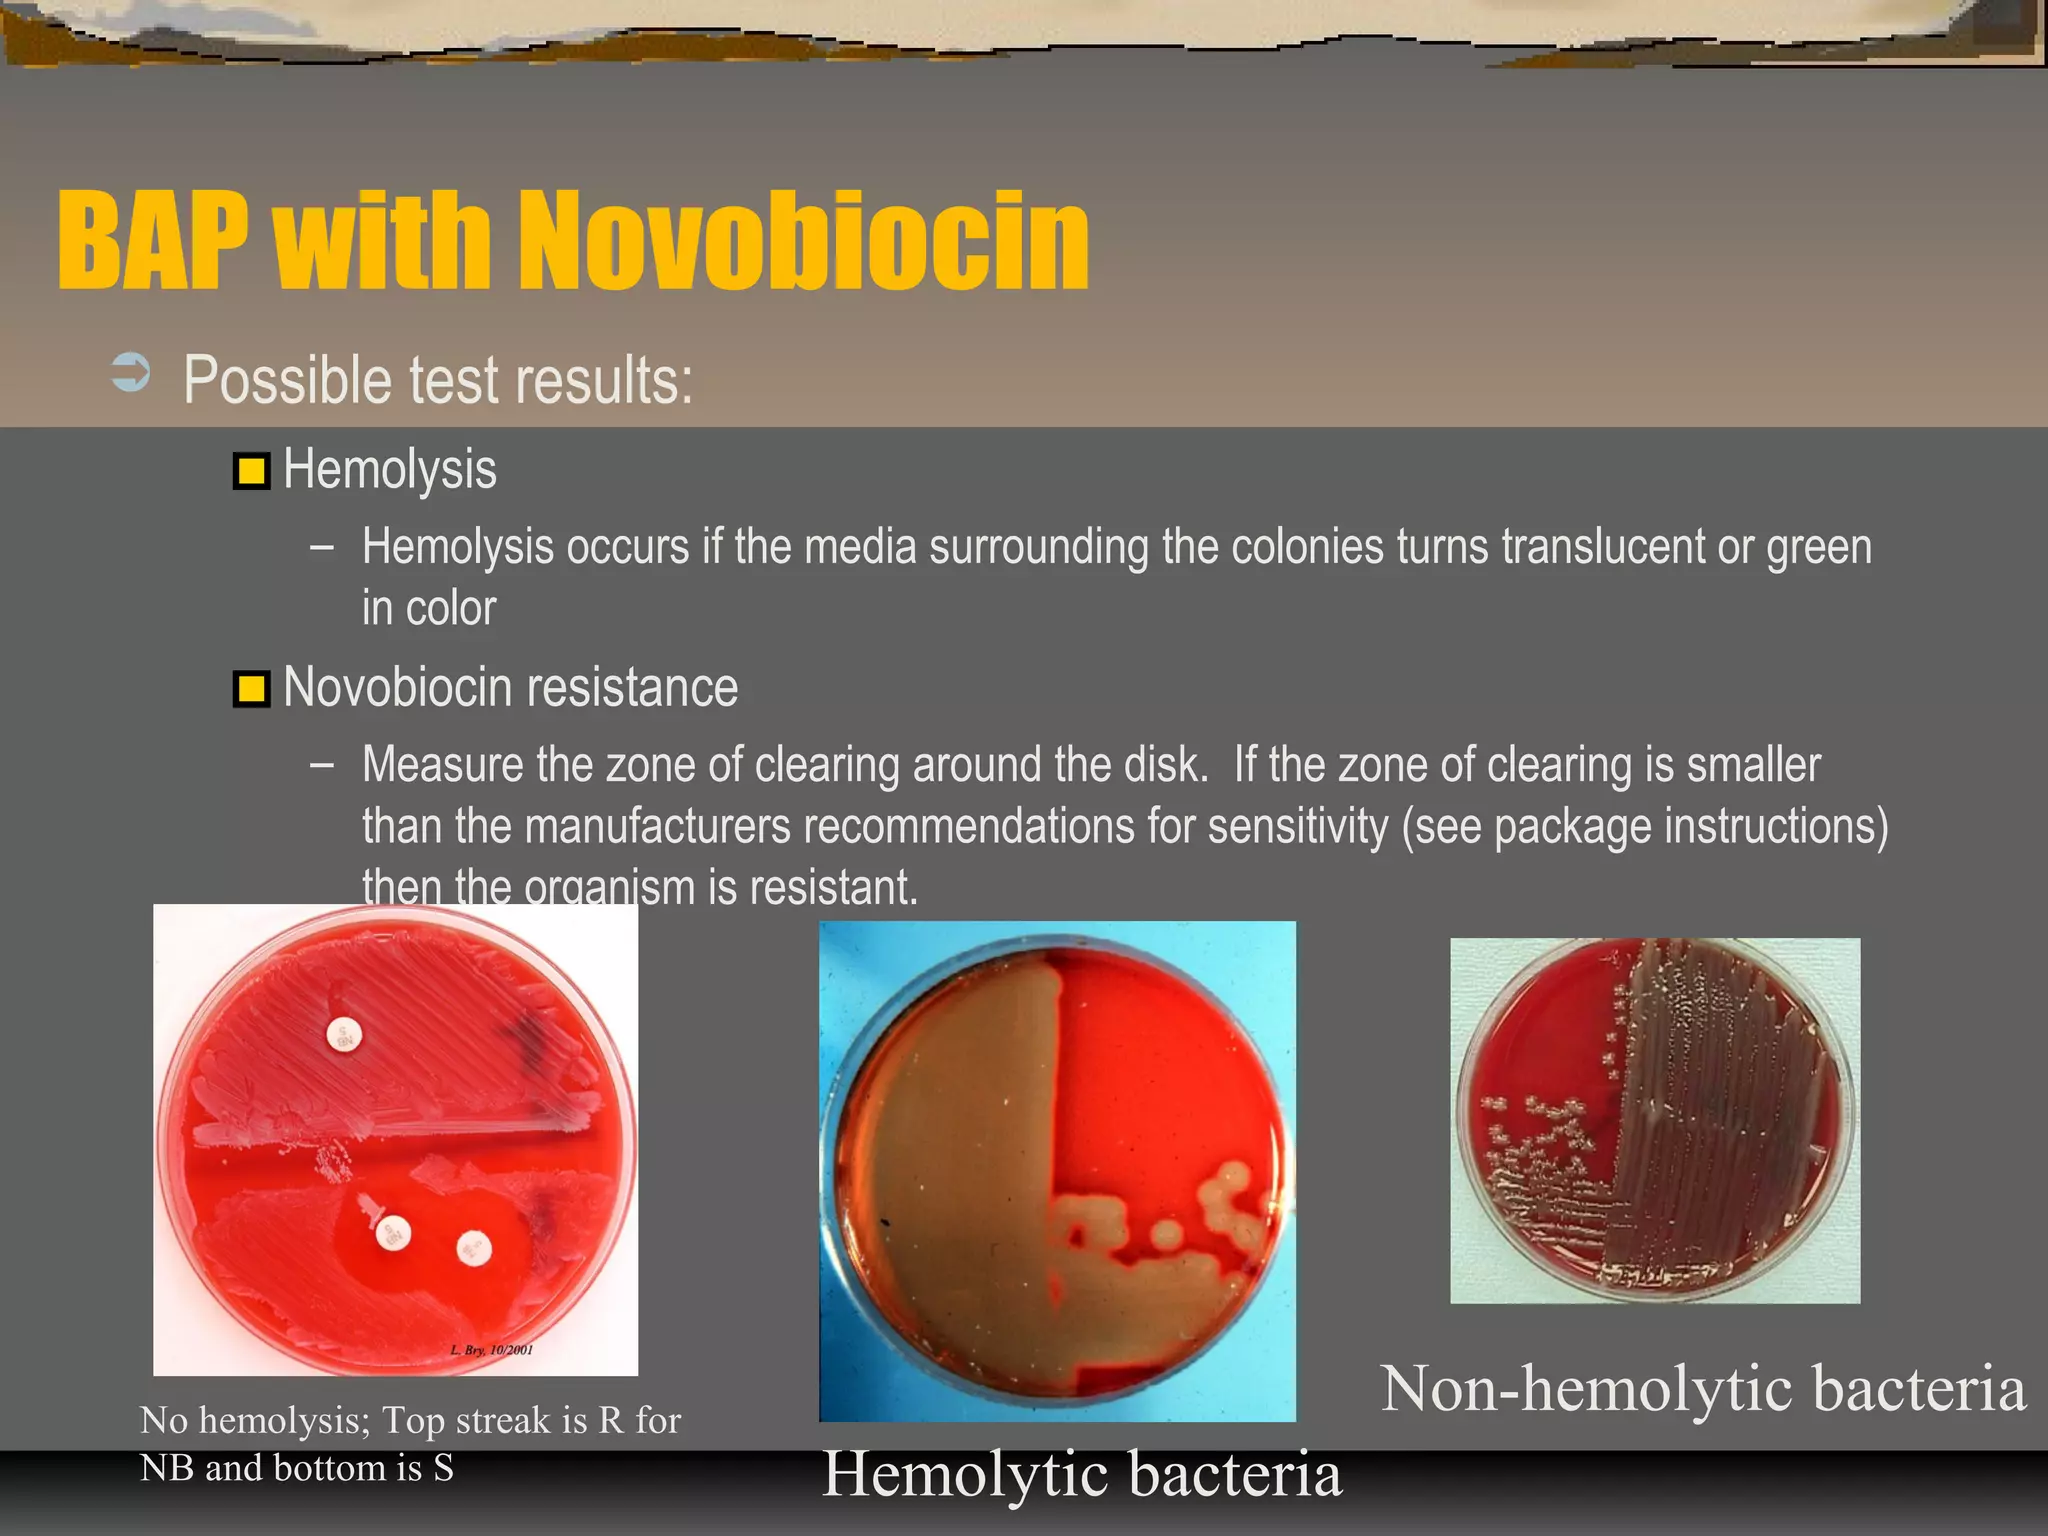
BAP with Novobiocin
 Possible test results:
Hemolysis
– Hemolysis occurs if the media surrounding the colonies turns translucent or green
in color
Novobiocin resistance
– Measure the zone of clearing around the disk. If the zone of clearing is smaller
than the manufacturers recommendations for sensitivity (see package instructions)
then the organism is resistant.
No hemolysis; Top streak is R for
NB and bottom is S Hemolytic bacteria
Non-hemolytic bacteria

The document outlines various biochemical tests for identifying and differentiating species of the Enterobacteriaceae family and Staphylococcus. It includes detailed procedures, properties being tested, media and reagents, as well as methods for interpreting results for tests such as indole, methyl red, Voges-Proskauer, citrate, H2S production, urea hydrolysis, motility, lactose and sucrose fermentation, glucose fermentation, and coagulase. Each test aims to determine specific capabilities of bacteria, aiding in proper identification.